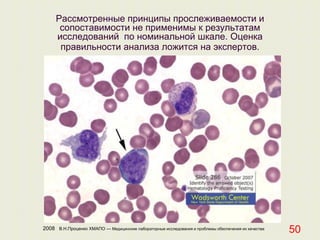
2008 В.Н.Проценко ХМАПО — Медицинские лабораторные исследования и проблемы обеспечения их качества
50
Рассмотренные принципы прослеживаемости и
сопоставимости не применимы к результатам
исследований по номинальной шкале. Оценка
правильности анализа ложится на экспертов.

Документ освещает проблемы обеспечения качества медицинских лабораторных исследований, с акцентом на значимость сопоставимости и прослеживаемости результатов. Главное условие для использования лабораторной информации заключается в том, что результаты должны быть сопоставимы во времени и пространстве. Упоминаются международные стандарты и подходы к созданию референтных систем для обеспечения метрологической прослеживаемости в лабораторной практике.